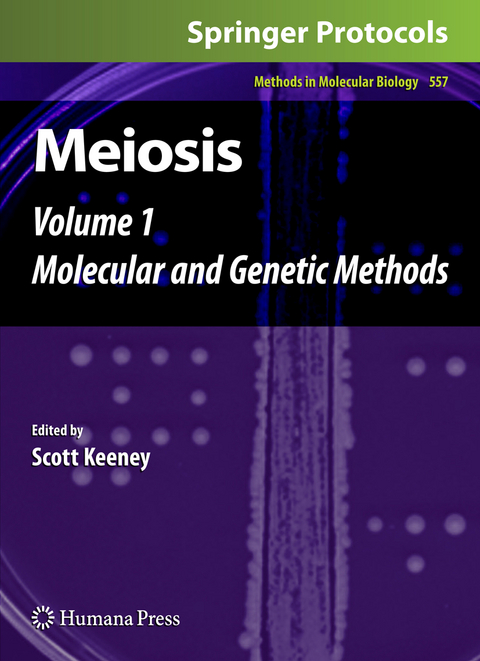
Meiosis -

Meiosis
Humana Press Inc. (Verlag)
978-1-934115-66-4 (ISBN)
Genetic Methods for Studying Meiotic Recombination and Chromosome Dynamics.- Interaction of Genetic and Environmental Factors in Saccharomyces cerevisiae Meiosis: The Devil is in the Details.- Optimizing Sporulation Conditions for Different Saccharomyces cerevisiae Strain Backgrounds.- Modulating and Targeting Meiotic Double-Strand Breaks in Saccharomyces cerevisiae.- Methods for Analysis of Crossover Interference in Saccharomyces cerevisiae.- Measurement of Spatial Proximity and Accessibility of Chromosomal Loci in Saccharomyces cerevisiae Using Cre?/loxP Site-Specific Recombination.- Genetic Analysis of Meiotic Recombination in Schizosaccharomyces pombe.- Analysis of Meiotic Recombination in Caenorhabditis elegans.- Visual Markers for Detecting Gene Conversion Directly in the Gametes of Arabidopsis thaliana.- Molecular Analysis of Recombination and Protein-DNA Interactions During Meiosis.- Gel Electrophoresis Assays for Analyzing DNA Double-Strand Breaks in Saccharomyces cerevisiae at Various Spatial Resolutions.- Genome-Wide Mapping of Meiotic DNA Double-Strand Breaks in Saccharomyces cerevisiae.- Detection of Meiotic DNA Breaks in Mouse Testicular Germ Cells.- End-Labeling and Analysis of Spo11-Oligonucleotide Complexes in Saccharomyces cerevisiae.- Detection of SPO11-Oligonucleotide Complexes from Mouse Testes.- Stabilization and Electrophoretic Analysis of Meiotic Recombination Intermediates in Saccharomyces cerevisiae.- Using Schizosaccharomyces pombe Meiosis to Analyze DNA Recombination Intermediates.- Analysis of Chromatin Structure at Meiotic DSB Sites in Yeasts.- Analysis of Protein–DNA Interactions During Meiosis by Quantitative Chromatin Immunoprecipitation (qChIP).- Genome-Wide High-Resolution Chromatin Immunoprecipitation of Meiotic ChromosomalProteins in Saccharomyces cerevisiae.- Parallel Detection of Crossovers and Noncrossovers in Mouse Germ Cells.- Analysis of Meiotic Recombination Products from Human Sperm.
| Reihe/Serie | Methods in Molecular Biology ; 557 |
|---|---|
| Zusatzinfo | XI, 365 p. |
| Verlagsort | Totowa, NJ |
| Sprache | englisch |
| Maße | 193 x 260 mm |
| Themenwelt | Naturwissenschaften ► Biologie ► Genetik / Molekularbiologie |
| Naturwissenschaften ► Biologie ► Mikrobiologie / Immunologie | |
| Naturwissenschaften ► Biologie ► Zellbiologie | |
| ISBN-10 | 1-934115-66-5 / 1934115665 |
| ISBN-13 | 978-1-934115-66-4 / 9781934115664 |
| Zustand | Neuware |
| Informationen gemäß Produktsicherheitsverordnung (GPSR) | |
| Haben Sie eine Frage zum Produkt? |
aus dem Bereich